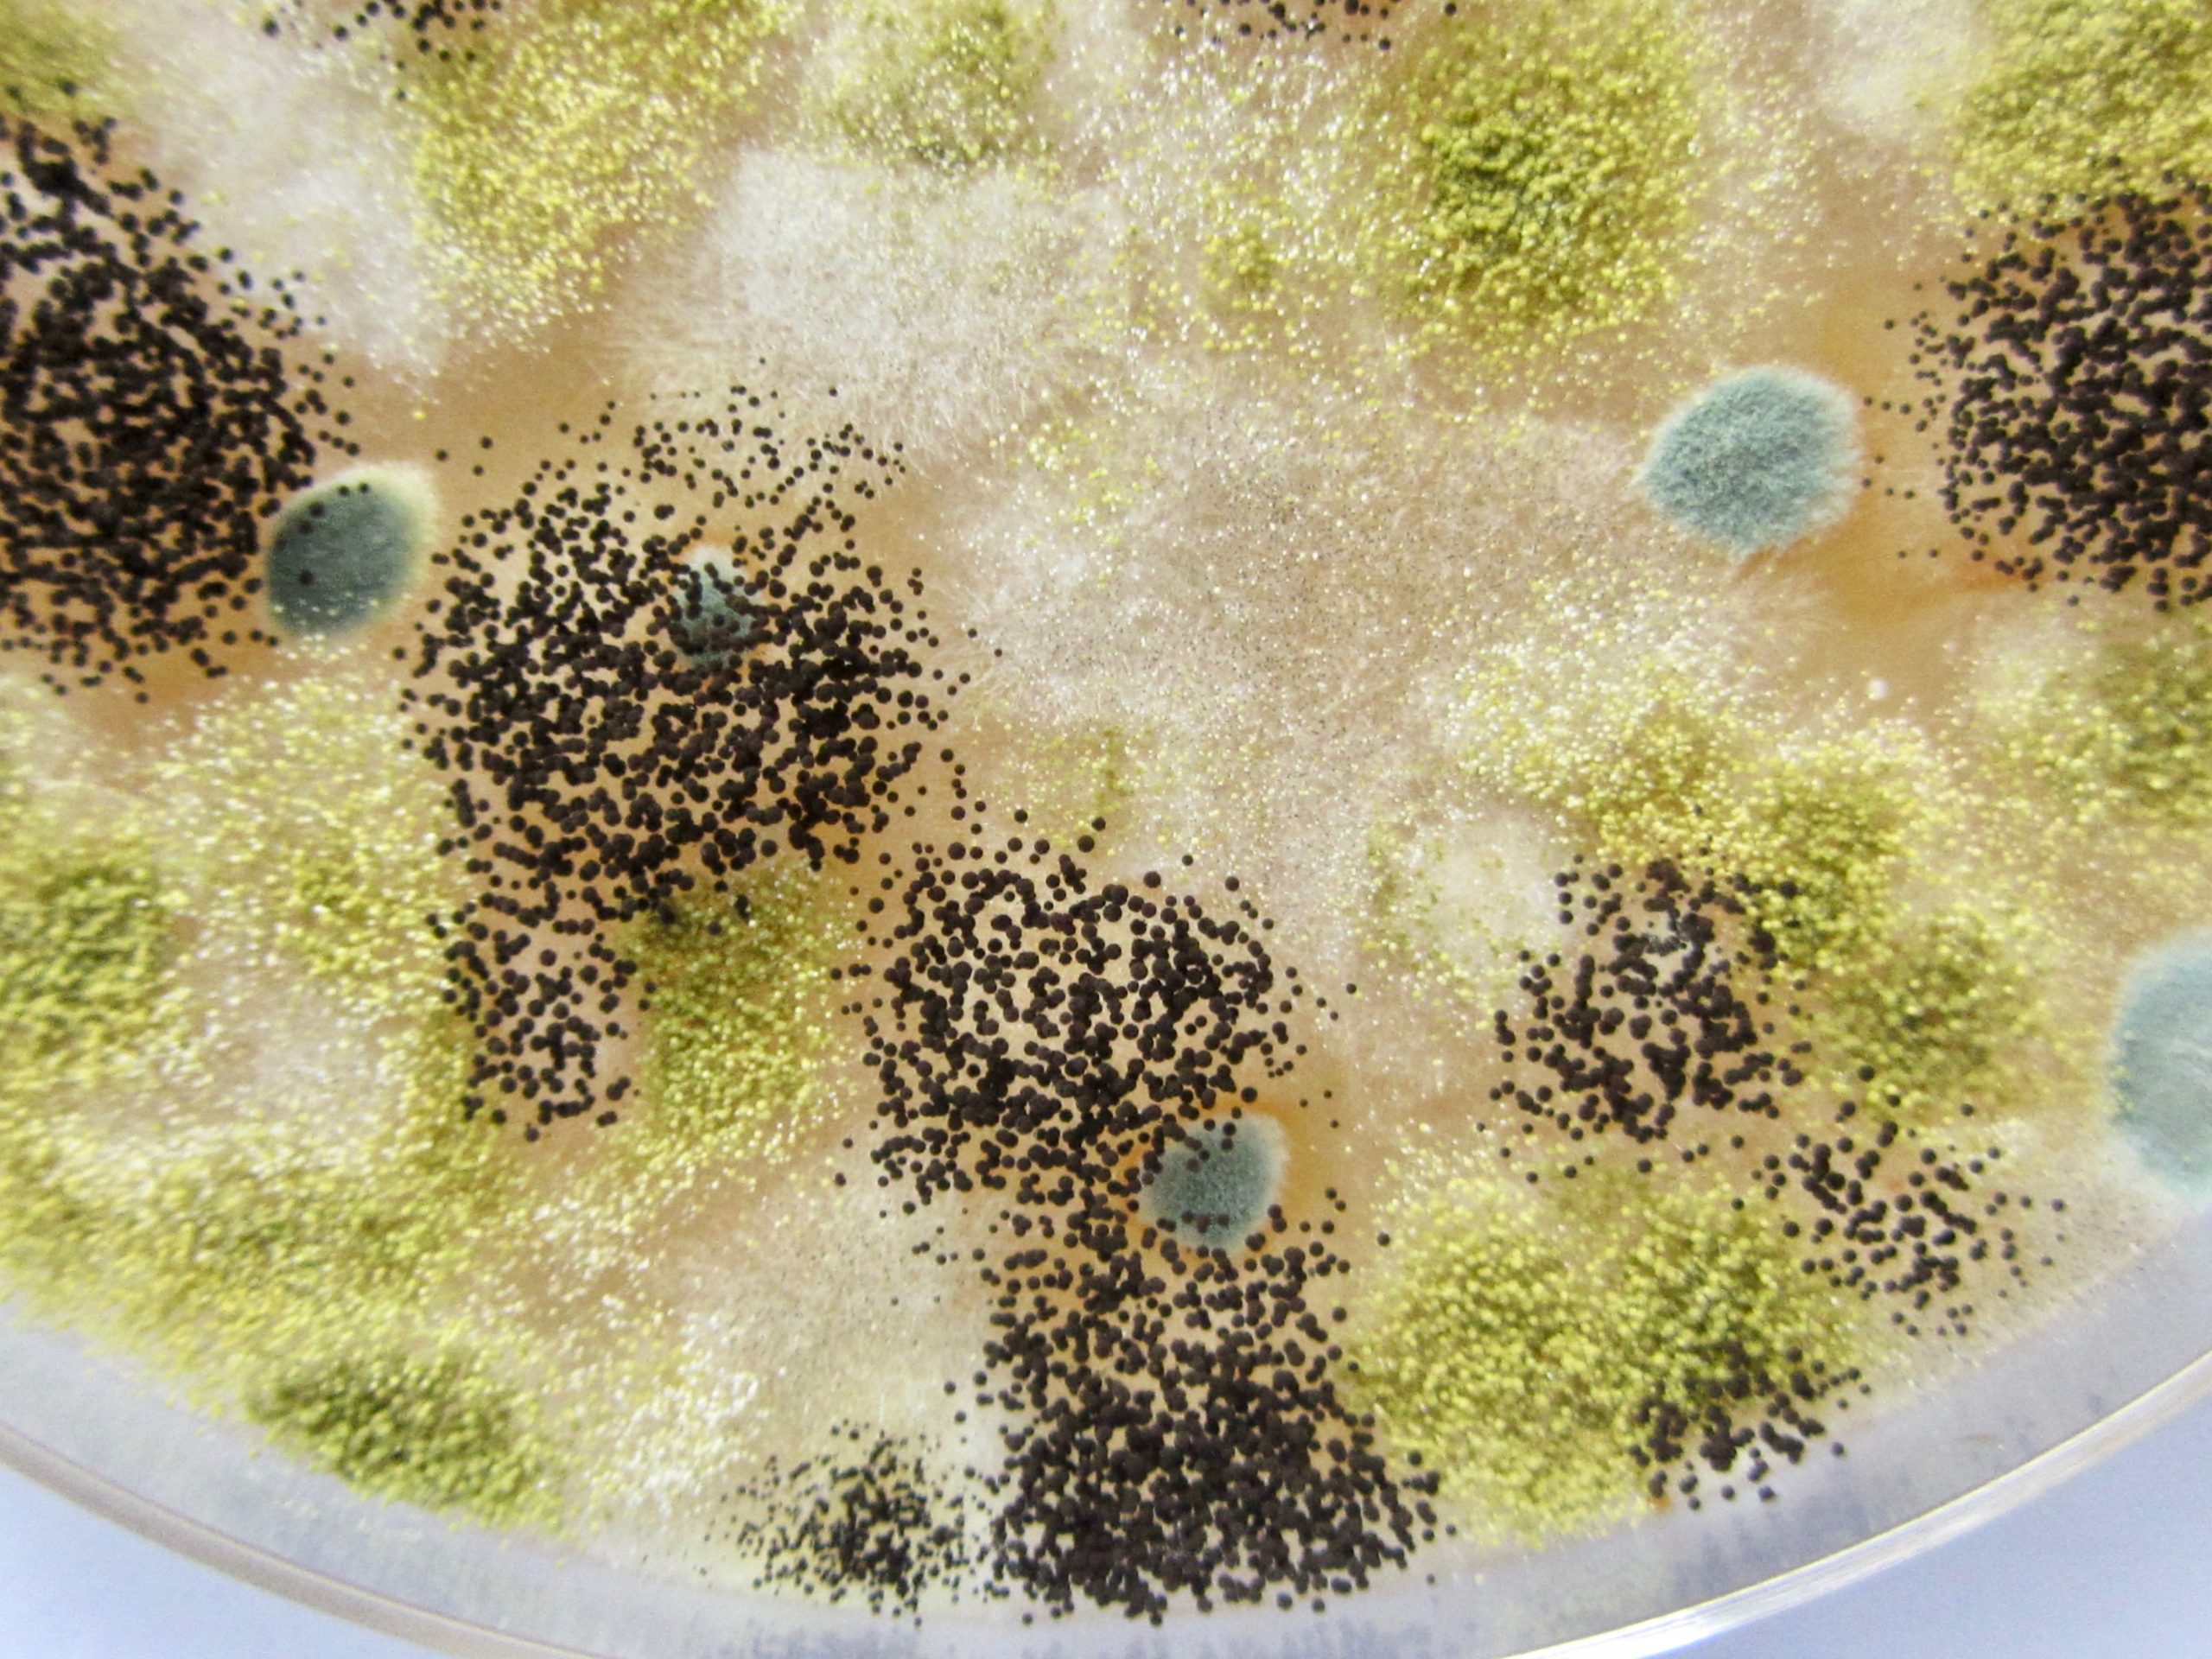
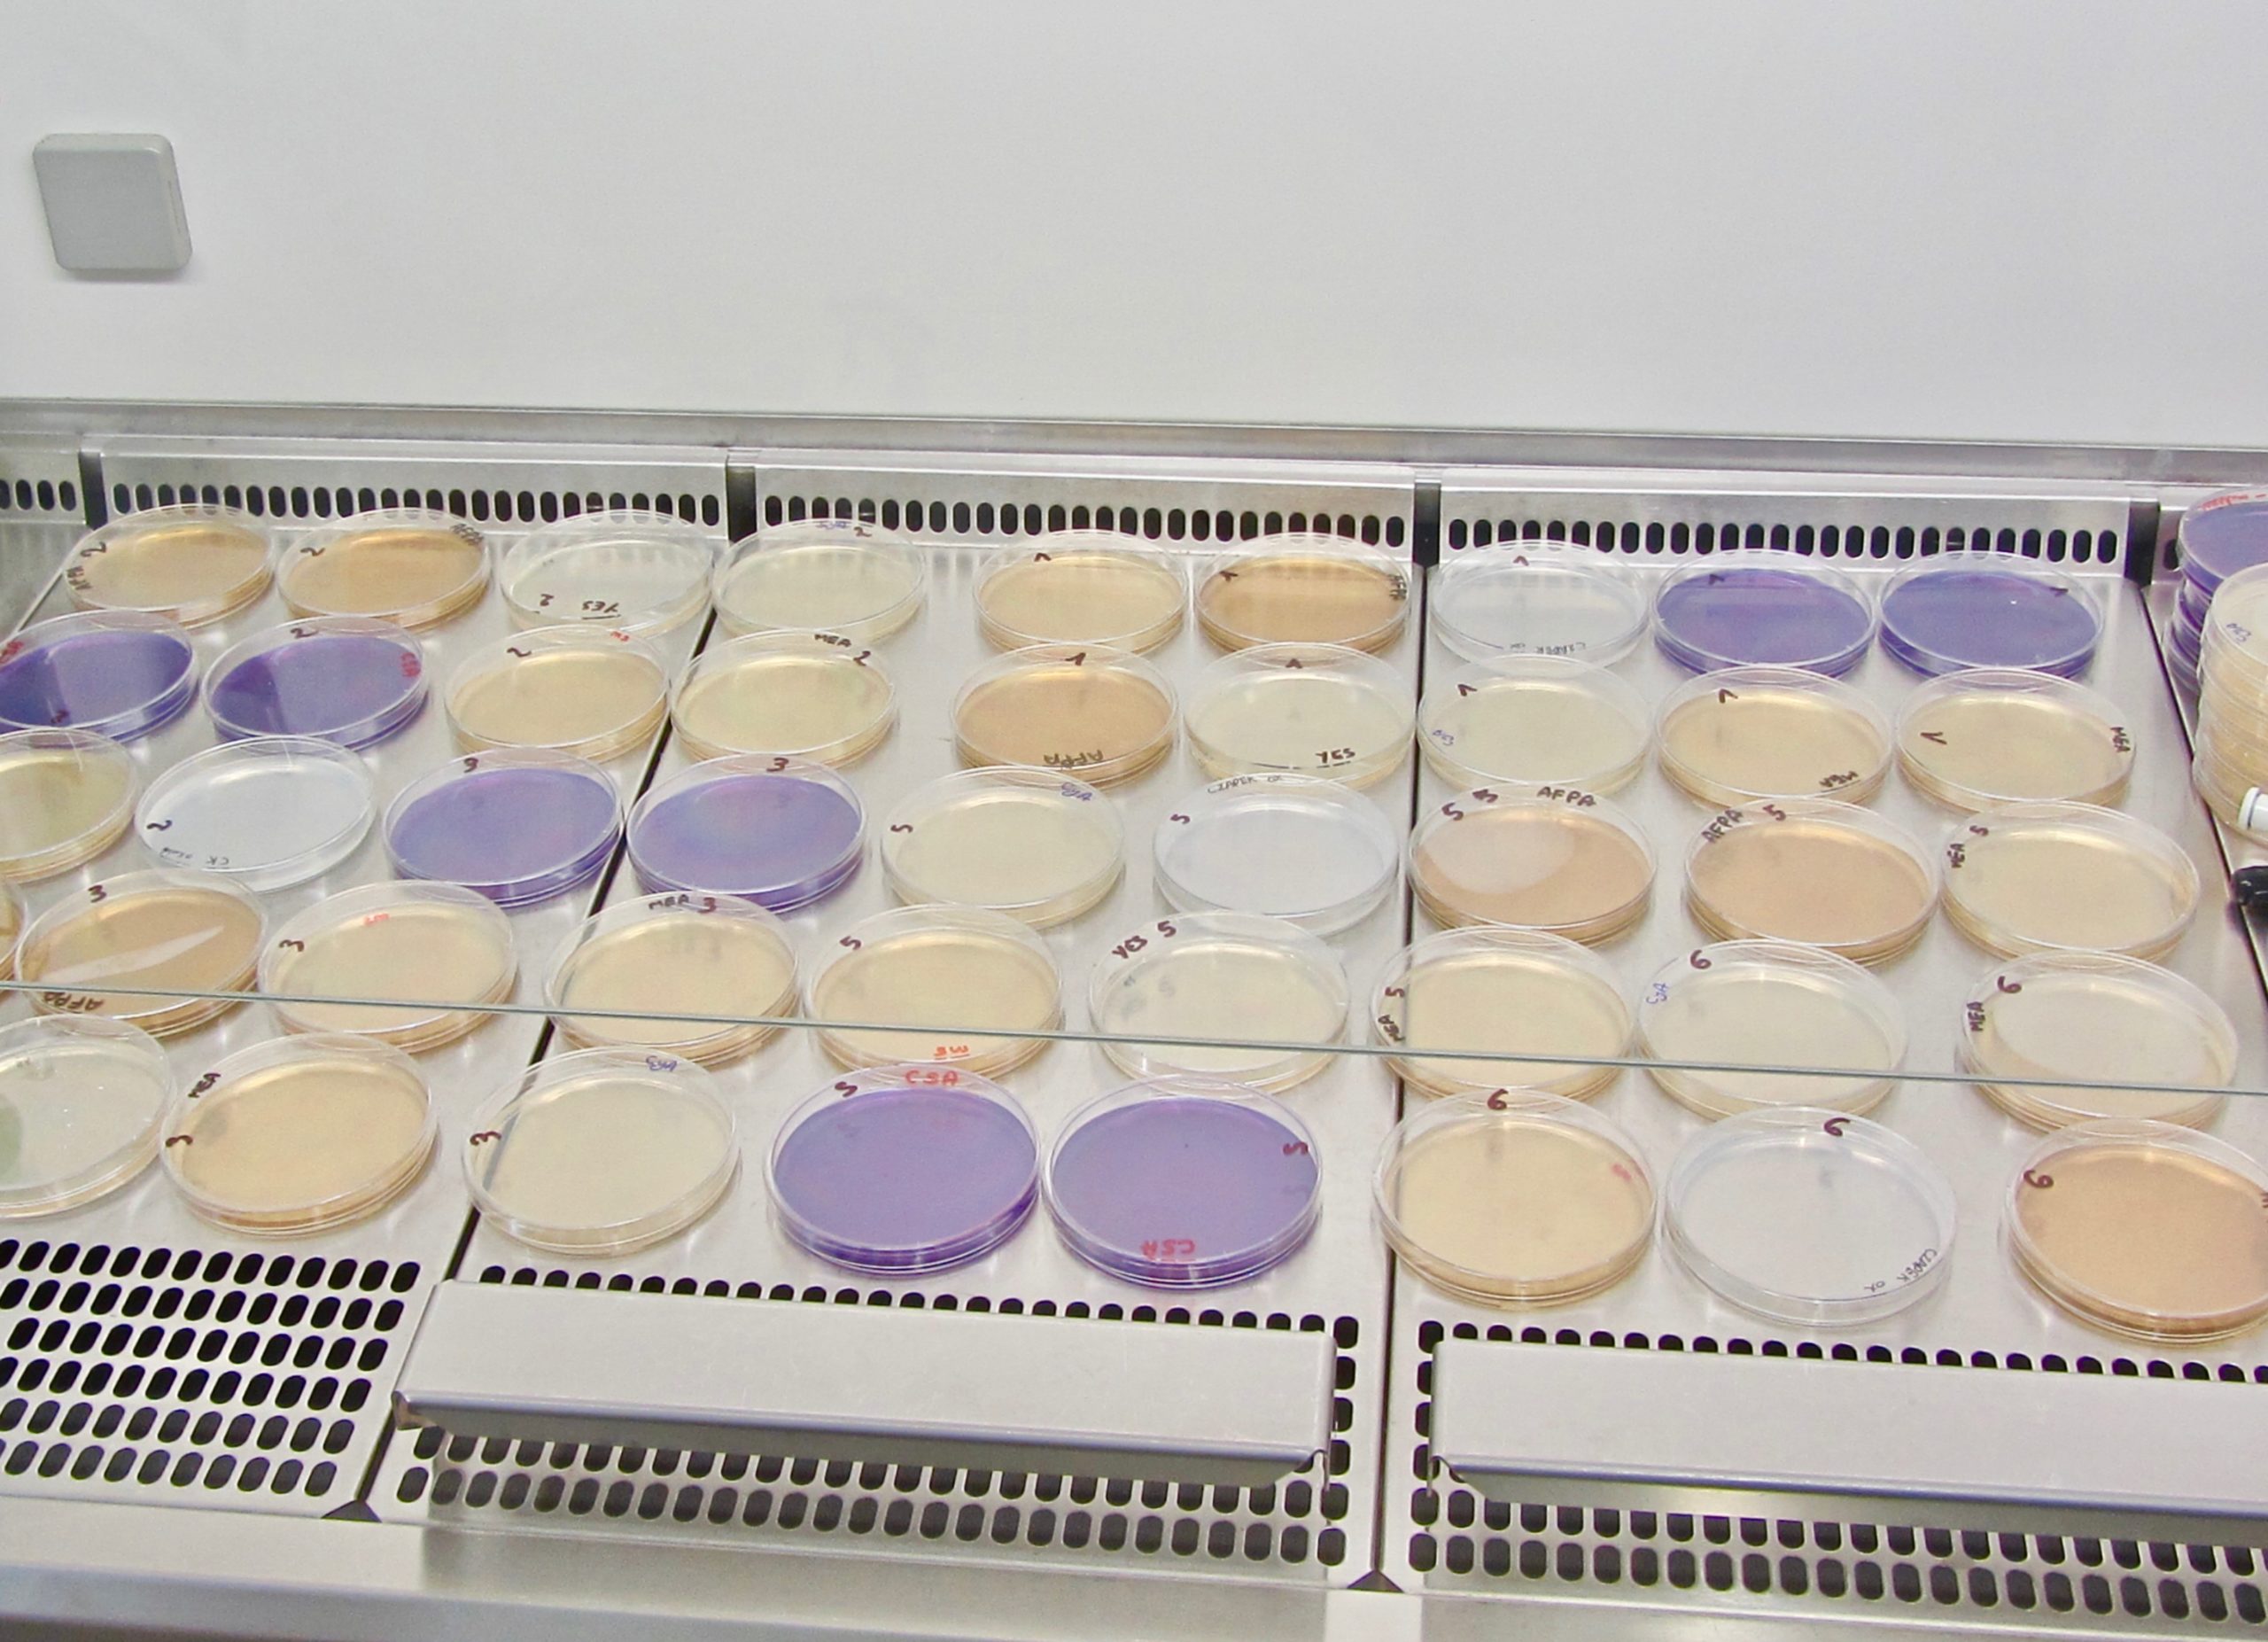

Nos Services
MYCOSCOPIA, UNE APPROCHE GLOBALE DES PROBLÉMATIQUES LIÉES AU DÉVELOPPEMENT FONGIQUE
NOTRE APPROCHE

Les problèmes liés aux moisissures sont souvent complexes et nécessitent une vision intégrée. Chaque cas est particulier. Ainsi, l’évaluation du risque sera fonction des espèces fongiques identifiées, de leur dénombrement, de la matrice sur laquelle elles se développent, de l’espèce animale-cible…
LES ANALYSES MYCOLOGIQUES
La mise en culture et l’analyse morphologique de critères macro et microscopiques permettent d’identifier l’ensemble des espèces fongiques présentes ou de rechercher une espèce particulière.
AUTRES SERVICES
MYCOSCOPIA : une longue expérience dans le domaine de la recherche et des compétences en mycologie au service de vos projets.
Ils nous ont fait confiance









.png)









